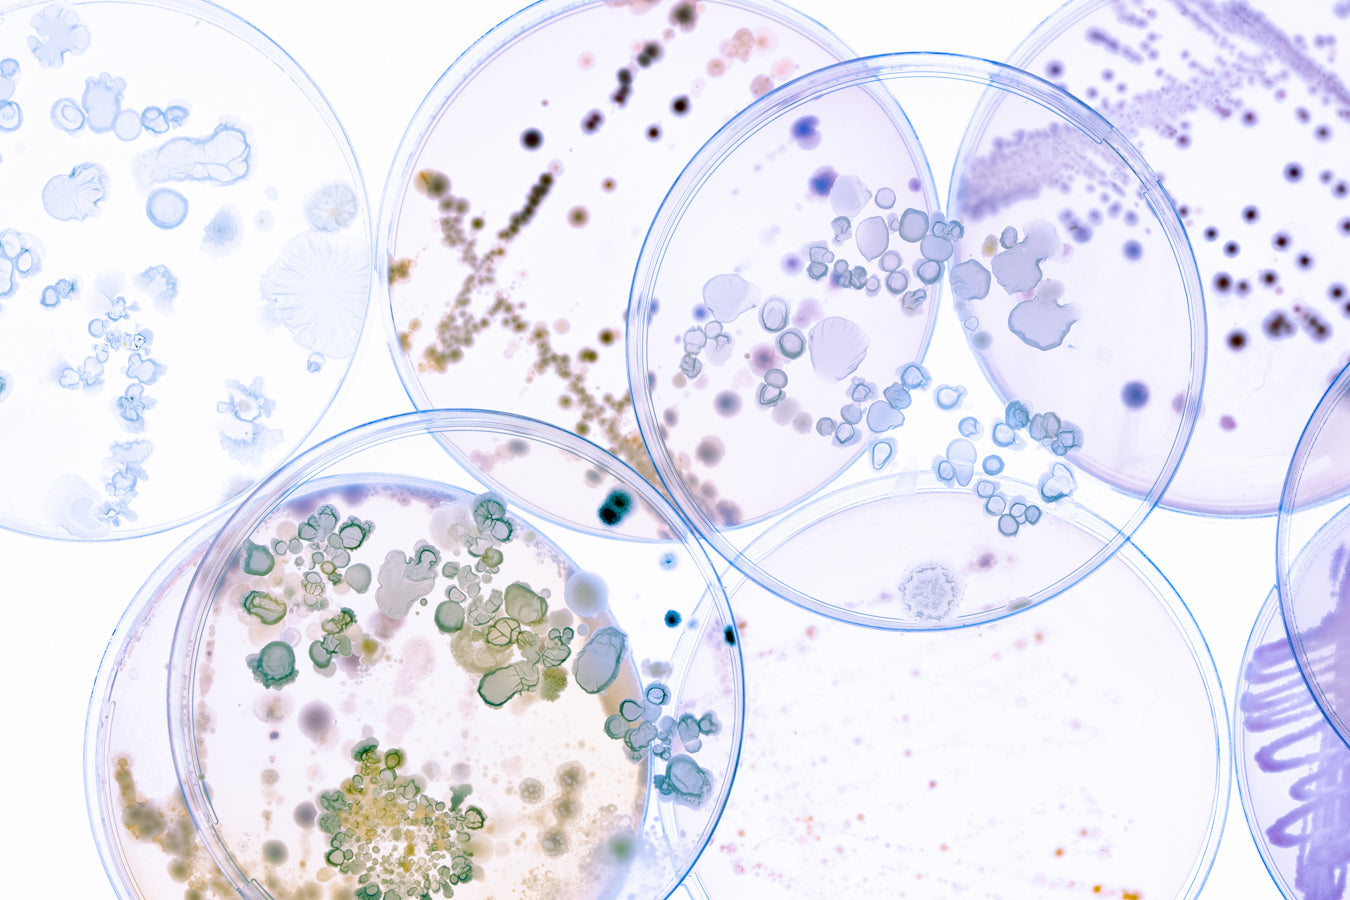

Probiotiques
Faible
Moyen
Élevé - Actifs premium
159.00 Dh
Prix unitaire parDes micro‑organismes sélectionnés pour soutenir l’équilibre du microbiote intestinal. Un microbiote harmonieux est lié au confort digestif et à une meilleure tolérance au quotidien (ballonnements, transit irrégulier, inconfort). L’intestin jouant aussi un rôle important dans l’immunité, les probiotiques sont souvent choisis quand on veut travailler “à la racine” : digestion + défenses.
Les Probiotiques Procure s’intègrent à une routine bien‑être orientée confort et régularité. Particulièrement utiles lors de périodes de stress, de changements alimentaires, de voyages ou après des phases qui perturbent l’équilibre intestinal, ils accompagnent une digestion plus sereine et une sensation de légèreté. Une solution simple pour prendre soin de l’intérieur, avec un impact visible sur le quotidien.
Spécification
Valeur
-
Gélule (bovine Halal)
-
Posologie
Jusqu’à 3 gélules par jour
-
Composition annoncée
“Composition pour 1 gélule par jour”
-
Capsule / excipients
Maltodextrine, Extrait d’amidon de maïs, Stéarate de magnésium
-
LOT
15APC22
-
PRD
01/2026
-
EXP
01/2029
-
Agrément ONSSA
CAPV.13.90.19
Ingrédients principaux
Souches probiotiques
Micro-organismes sélectionnés pour soutenir l’équilibre du microbiote et le confort digestif au quotidien.

Support / excipients
Protègent et stabilisent les souches (selon la composition indiquée sur l’étiquette).
Questions fréquentes
Ce sont des probiotiques destinés à soutenir l’équilibre du microbiote intestinal. Ils sont souvent utilisés pour améliorer le confort digestif (ballonnements, transit irrégulier, inconfort) et soutenir l’équilibre général.
Lors de périodes de stress, changements alimentaires, voyages, ou quand la digestion est moins stable. L’objectif est de rééquilibrer “à la base” et retrouver plus de régularité et de légèreté.
La posologie exacte dépend de votre produit : suivez ce qui est écrit sur l’étiquette. La composition affichée correspond toujours à la portion indiquée (par jour).
Ça varie selon les personnes et le contexte. En général, on vise une prise régulière sur plusieurs semaines pour évaluer le confort digestif et la stabilité du transit.
Oui. Ils se combinent bien avec des routines “confort + énergie” (ex. Magnésium, Vitamine C, Oméga) selon votre objectif, en évitant les doublons et en respectant les posologies.
Si vous avez une condition médicale spécifique, un système immunitaire fragilisé, êtes enceinte/allaitante ou suivez un traitement, mieux vaut demander l’avis d’un professionnel avant de commencer.


